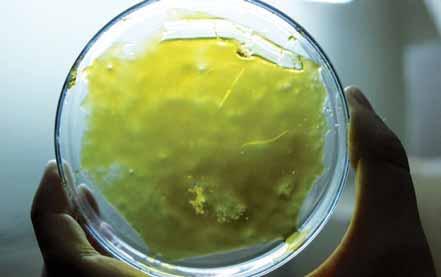

6 minute read
Buddder
from 2012 05 ES
by SoftSecrets
Del BHO al Budder
Miky Pérez
Gracias a los chicos de Growland, que nos abren sus puertas y comparten con nosotros sus experiencias y sabiduría, aprenderemos a realizar una extracción de cannabinoides con gas butano. Growland se trata de una floristería especializada, es decir un growshop, que nace en Madrid con el afán de aportar algo positivo a la comunidad cannábica. Estos chicos se han especializado en extracciones y enseñan a todo aquel que quiera aprender. Y no hablamos de las clásicas extracciones de polen con hielo o en seco, ni la moderna técnica del NitroHash… nos referimos a aceites puros de cannabis: una delicia para el paladar, un subidón de locos y un efecto medicinal inmejorable.

A modo de síntesis, el BHO (Butane Honey Oil, o en español miel de aceite de butano) es una extracción de cannabinoides que se realiza haciendo pasar el gas butano por la marihuana. El líquido que sale al mezclar los componentes, cuando se evapora todo el gas, deja un residuo que en frío se rompe como el cristal más frágil y en caliente es idéntico a la miel (tanto por color, textura y densidad), de ahí su nombre.
Esta “miel” es muy popular en Estados Unidos, Holanda y Canadá tanto en los círculos más sibaritas y sobre todo entre los usuarios medicinales. Para los consumidores únicamente medicinales, estos aceites son muy prácticos ya que se pueden diluir con otros aceites (de oliva, por ejemplo) lo cual hace mucho más sencillo ajustar la dosis a cada paciente, tanto así que se consigan sólo los efectos deseados, sin llegar a notar efectos psicoactivos (es decir, que no llegue a “colocar”). Por otra parte, se trata de una materia muy transportable, de la cual sólo se necesitan cantidades muy bajas debido a la alta concentración de cannabinoides.
¿Qué nos hace falta?
Para hacer una extracción perfecta y sin residuo alguno o resto de gas, los chicos de Growland nos aconsejan utilizar material de calidad, lo dicen no tanto por la materia prima, sino por los instrumentos a utilizar.
En esta extracción de BHO hemos utilizado los siguientes instrumentos: un tubo de acero, que puede ser de otro material o incluso de acero quirúrgico, pero en cuanto a relación calidad-precio el consejo de Growland es uno de acero (el diámetro o la longitud sólo hará variar la cantidad de hierba y butano a gastar); un trozo de malla de acero de 50 micras que recubra un extremo de nuestro tubo y algún tipo de presa para sujetarla (nunca usar una goma elástica que se disuelven con el butano); un tapón de goma con una abertura en medio que sirva para el diámetro de nuestro tubo; gas butano, lo más sencillo es usar las botellas de gas para recargar mecheros (la calidad de la extracción dependerá del gas que utilicemos); dos fuentes de cocina para hacer un baño maría, por lo que una tiene que caber en la otra (lo idóneo son fuentes de cristal); unas cuchillas o cúter para poder recoger cómoda y limpiamente nuestro aceite.
Hasta aquí el material básico necesario para hacer una extracción de calidad, pero como os comentamos, vamos a aprender a hacer también budder, por lo que también usaremos un par de máquinas para su limpieza. Se trata de una pequeña bomba de vacío conectada a una desecadora y una placa de Petri (platito científico de cristal) para colocar la extracción a limpiar.


El proceso de extracción
Ya tenemos todos los materiales dispuestos y la materia prima preparada. La hierba que usemos, no hace falta que sean cogollos de primerísima calidad (que siempre quedará mejor) pero se pueden usar los restos o los recortes secos de nuestras plantas. Metemos la hierba que quepa y sin prensarla mucho en nuestro tubo, tapamos y lo metemos una hora en el congelador. Si el tubo es de metal, es imprescindible usar guantes o trapos para sujetarlo después de congelarlo y durante la extracción. Vamos calentando el agua hasta que hierva para nuestro baño maría con las fuentes de cristal, una vez colocadas y calientes comenzamos la extracción.
Enchufamos el bote de gas con su boquilla correspondiente al tapón de goma de nuestro tubo y apuntamos con el otro extremo hacia las bandejas del baño maría. El siguiente paso es recomendable hacerlo al aire libre. Apretamos y el bote suelta el gas, que comienza a pasar por toda la hierba y al cabo de unos segundos empieza a salir un líquido marrón. Mientras sale el gas líquido con los cannabinoides, vamos pintando la superficie de la bandeja descargando uniformemente la extracción. Es mejor hacerlo en dos tandas, gastas medio bote, esperas un par de minutos y vuelves a repetir. Si hemos usado grandes cantidades de marihuana, tendremos que usar más gas. La proporción viene a ser aproximadamente el doble de gas que la cantidad de hierba empleada. Pues la extracción ya está hecha, sólo quedaría quitarle el gas.
Budder
Normalmente la gente no tiene una bomba de vacío y una desecadora en su casa, por lo que suelen quitarle el gas explotando las burbujas de gas rallando la extracción con un palillo. Nosotros lo recogimos todo con una cuchilla y lo extendimos en la placa de Petri. Con toda la “manteca” untada, colocamos el petri en el centro de la desecadora, cerramos, conectamos a la bomba de vacío y la encendemos. Es realmente sorprendente lo que sucede aquí, toda la extracción comienza a inflarse, se convierte en una esponja y luego comienza a bajar otra vez.
Esto es el gas separándose de los cannabinoides. Este proceso se repite las veces que uno quiera y para ello tienes que colocar el petri en las fuentes calientes, cada vez que lo quieras colocar en la desecadora de nuevo. Nosotros llegamos a realizar este proceso hasta cinco veces antes de considerarla “lista para el consumo”. El resultado es una extracción de primera calidad, un auténtico BHO totalmente limpio de gas con una concentración de THC entre el 60 y 70%. Bodegón con todo lo necesario
Pintando la superficie con gas y cannabinoides
Lo recogemos todo y extendemos en el petri
La extracción inflándose dentro de la desecadora


El budder de cerca
La Grow – Ripper Seeds
Como guinda al artículo anterior, donde vimos como limpiar el BHO con una bomba de vacio para conseguir Budder, os dejamos una colección de fotos de este proceso realizadas por el equipo de la Grow / Ripper Seeds. Atención a como se hincha el aceite al ser purgado al vacío.




